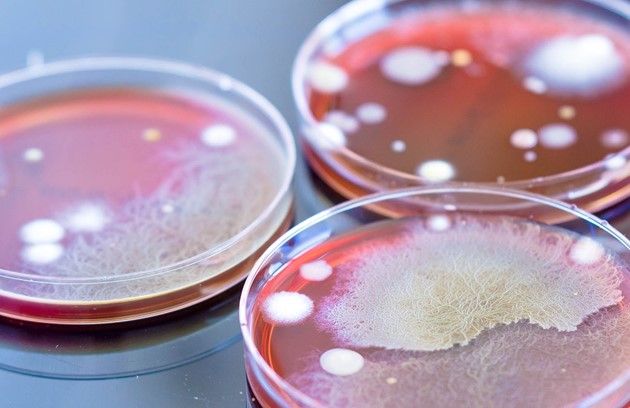

Anatomic Pathology
NRL brings to the region world-class specialty-oriented anatomic pathology (AP) services, connecting referring physicians with locally present sub-specialized pathology experts. NRL’s offering covers the complete range of AP services: primary diagnosis, second opinion and e-pathology to cater for the needs of our clients.
The availability of in-country subspecialized anatomic pathology services brings multiple benefits to the medical professionals and the patients in the UAE and the region. The quicker turnaround time and the possibility for direct interaction between the referring physician and the reporting pathologists facilitate a faster and more precise diagnosis. Furthermore, the availability of e-pathology consultations ensures direct access to an extensive network of experienced pathologists for the interpretation of the most challenging cases.
Hematopathology
Hematopathology is part of our surgical pathology offering, NRL provides comprehensive diagnostic services and professional expertise relating to disorders of the blood and blood forming tissues, bone marrow, lymph nodes, spleen and thymus.
In addition to conventional histology, a variety of specialized immunological, molecular, cytogenetic, FISH and flow cytometric tests are performed routinely and are integrated by our scientific team into diagnostic reports.
For hematology/oncology patients we provide immunophenotyping flow cytometry assays and analysis of T-, B- and NK- cell populations.
Infectious Diseases and Tuberculosis
The Advanced Diagnostic Centre for Infectious Diseases and Tuberculosis testing implements all quality performance standards required to safely and effectively culture and identify wide range of bacteria and fungi.
NRL has ensured that its laboratory, with intricate design, containment, and equipment capabilities, comply with requirements for a Biosafety Level 3 (BSL-3) laboratory.
We offer susceptibility of mycobacterium tuberculosis including the first line drugs and second line drugs in case of multidrug-resistant TB - giving an expanded testing for MDR TB is essential for the quick determination of the most appropriate therapy regimen for patients and maximize their chance of recovery. In addition to the chromatographic immunoassay for the qualitative detection of mycobacterium tuberculosis complex (MTbc) from an AFB smear-positive MGIT tube, as well as, molecular detection by PCR, and Rifampin resistance by nucleic acid amplification (NAA).
Molecular Diagnostics and Genomics
NRL is one of the few laboratories in the region that offers in-country world class, genetic testing to serve healthcare providers and patients. This ultimately enables us to ensure that the testing is performed to the highest quality and at a faster turnaround time, reducing patient anxiety.
Our Genomics Laboratory is committed to scientific advancement and test development through a highly experienced and highly dedicated team. Our current test offering has been developed inline with the needs of the region and includes: hereditary cancers, hemoglobinopathies, Non-Invasive Prenatal Testing (NIPT) and newborn screening. We also offer genetic counselling support for patients, both pre-and post- testing.
Special Chemistry
The Special Chemistry Laboratory provides a broad range of testing to detect, diagnose and treat many diseases such as cancers, infectious diseases, organ specific disorders and newborn genetic and metabolic conditions. Special Chemistry compliments and overlaps with many of the other laboratory services.
A unique section of Special Chemistry focuses on proteins produced in the body that can signal the onset of cancer, changes to the immune system including autoimmunity and recovery during treatment.
The laboratory also provides forensic drug testing which helps companies keep their workplace drug free and safe for all workers.
In addition, the laboratory offers consultative services and often takes a proactive approach to assist clinicians when there are unusual findings.
Special Coagulation
The Coagulation Laboratory provides consultations and diagnostic studies related to the problems of haemorrhage and thrombosis. In addition to regular studies, the laboratory is capable of assaying for all coagulation factors, factor inhibitors, platelet function tests and antithrombin III.
Hypercoagulability (thrombophilia) and bleeding disorders can be life threatening and impact the quality of life of the patient and their family. NRL’s test offering and scientific team helps physicians with the diagnosis and management of disorders including rare conditions.
Transplant Immunology
The Transplant Immunology and Flow Cytometry Laboratory is focused on providing a unique and high quality service for solid organs and bone marrow transplant activities.
Our histocompatibility test offering for solid organs and bone marrow includes medium/high level Human Leukocyte Antigen (HLA) typing for transplant recipients and donors both local and international transplant programs. We also perform testing for specific genes which are associated with development/risk of certain diseases.
In addition, pre- and post-transplant monitoring of kidney transplant recipients represents a substantial component of our transplant service offering including flow cytometry cross match and highly sensitive solid phase methodology for antibody analysis.
Newborn Screening
NRL’s Newborn Screening Centre providescomprehensive, high-quality testing to detectmetabolic, endocrine, and genetic disorders innewborns before symptoms appear. Throughadvanced analytical platforms and strict qualityprotocols, NRL delivers accurate, timely, andclinically actionable results.
Aligned with the DOH National NewbornScreening Guidelines, NRL ensures diagnosticexcellence, data integrity, and patient safety —setting new standards in neonatal care.
Neurobiochemical Diagnostics (Alzheimer’s)
NRL’s Neurobiochemical Diagnostics Centre serves as a regional hub for advanced biomarker testing that supports early detection and monitoring of neurodegenerative disorders such as Alzheimer’s disease. Through in-house blood testing, clinicians gain access to non-invasive, quantitative insights that enhance diagnostic precision and patient care. Utilizing validated biomarkers, NRL upholds international standards of quality, research, and innovation in neurodiagnostic excellence across the UAE and MENA region.
Wellbeing
NRL advances preventive health and wellness diagnostics through science, innovation, and precision care — empowering individuals and physicians to take a proactive approach to wellbeing. Our evidence-based panels support metabolic, hormonal, cardiovascular, and nutritional assessments for early risk detection.
Integrated within the M42 Diagnostics Network and guided by ISO-accredited quality systems, NRL delivers clinically accurate, data-driven insights that enable personalized prevention and long-term wellness management.